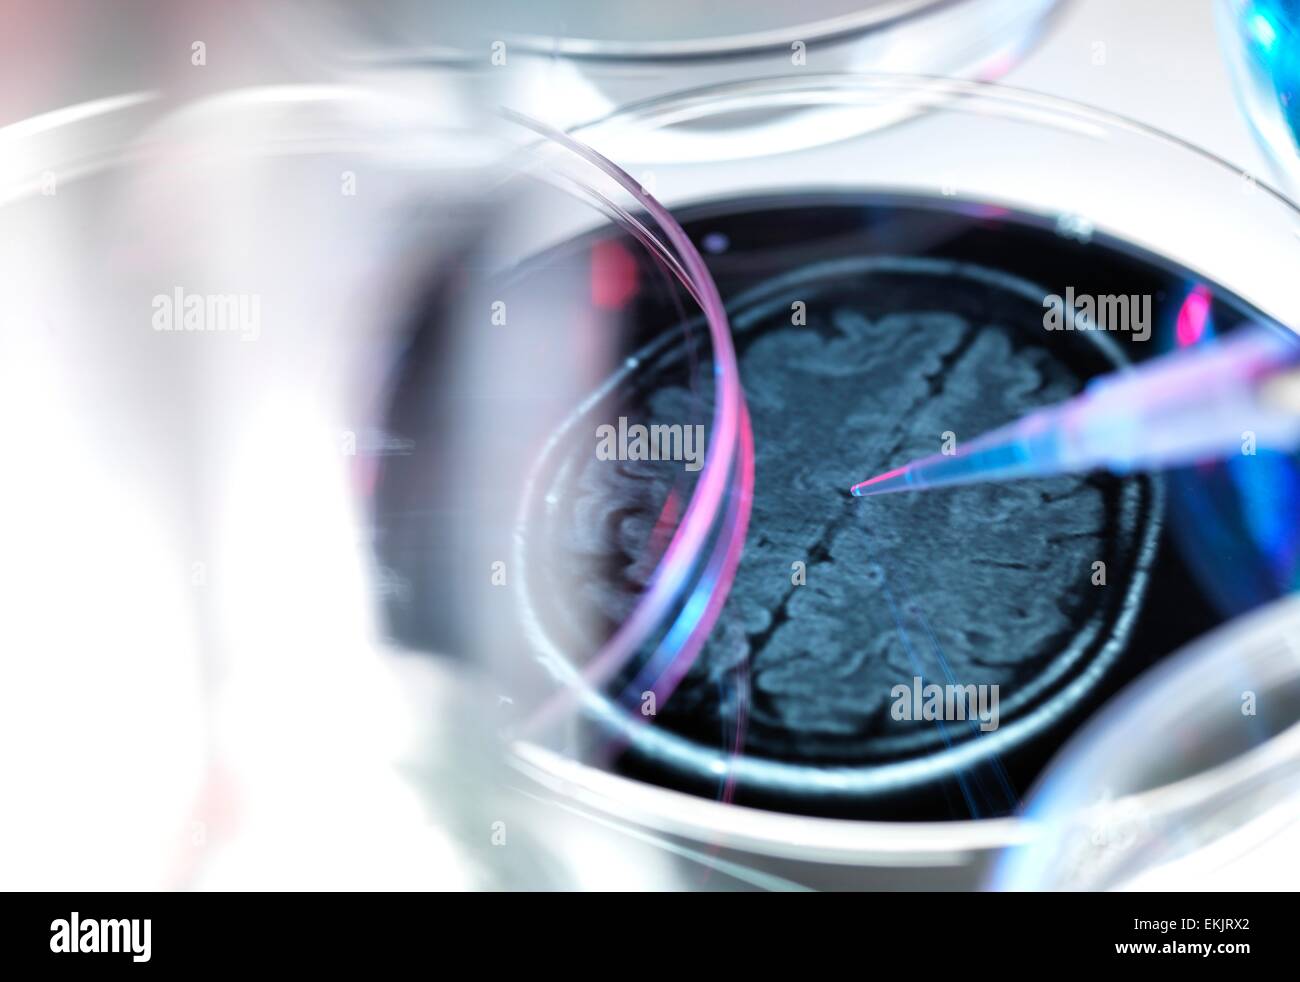
Il morbo di Alzheimer, il morbo di Alzheimer'ss malattia, malattia di Alzheimer, atrofia, cervello, la demenza, malattia, disturbo, sanitario, medico, la medicina, la demenza senile, ricerca, petri, pipetta, la ricerca farmaceutica, laboratorio Foto Stock

Malattia di alzheimer Immagini Stock
(14,098)Filtri rapidi:
Malattia di alzheimer Immagini Stock

RFPG98FD–La proteina amiloide nella malattia di Alzheimer. Illustrazione dei processi che portano alla formazione di placche amiloidi (fasci aggrovigliati) sui neuroni (cellule nervose, blu). Placche amiloidi sono caratteristiche della malattia di Alzheimer. Essi conducono alla degenerazione dei neuroni interessati. I processi cellulari mostrato qui avviene dopo la beta-peptide amiloide è stata scissa dalla gamma e beta secretasi. Il residuo di amiloide lascia la membrana cellulare, cambia forma e si aggrega in lunghe fibrille. Queste fibrille formare dense le placche su cellule nervose.

RF2CE12PN–Placche amiloidi che si formano tra neuroni. Proteina beta-amiloide che disturba la funzione delle cellule nervose in un cervello con malattia di Alzheimer

RFH9EARK–La malattia di Alzheimer e il morbo di alzheimer genetica come testo con una doppia elica di DNA filamento come una demenza salute mentale e disturbi neurologici medici di terapia genica un

RME60KTD–Il tecnico aiutando un medico specialista con un cervello virtuale di calibrazione di ricerca che sta facendo la ricerca sul morbo di Alzheimer

RFT847WG–Visualizzazione medico paziente scansione cerebrale sulla tavoletta digitale in laboratorio

RF2G4KR33–Malattia di Alzheimer che colpiscono e distruggono la vita umana - simboleggiata da una figura in saccheggio per mostrare l'effetto della malattia di Alzheimer e quanto male, limitante

RFBJ1FM4–Una donna anziana affetti dal morbo di Alzheimer, in una casa residenziale specializzati nella cura di persone con demenza.

RFFRW300–Figlia adulta parla con sua madre con la malattia di Alzheimer nella sua stanza in una casa di riposo

RFHYR36E–Cervello malattie degenerative, morbo di Parkinson, Sinapsi, neuroni, il morbo di Alzheimer, rendering 3D

RMBT25EA–La vitamina D compresse (utile per il morbo di Alzheimer - la mancanza di questa vitamina è legato al cancro, la sclerosi multipla e il rachitismo)

RF2BK9YB4–Disintegrazione del cervello umano o rottura dell'illustrazione del rendering 3D. Disturbi della memoria, malattie neurologiche come il morbo di Parkinson o il morbo di Alzheimer, amn

RFT0RHRC–Il morbo di Alzheimer e demenza segni e sintomi, senior e la cura delle malattie neurodegenerative concept

RFF5PKGA–Il morbo di Alzheimer. Computer illustrazione delle placche amiloidi tra neuroni. Placche amiloidi sono caratteristiche di

RF2D3AJAA–La proteina beta amiloide/placca amiloide e l'aggregato proteico Tau/groviglio neurofibrillare sono primari Marcatori per la malattia di Alzheimer

RF2BDN5B9–Alzheimers e demenza concetto di malattia di perdita di memoria e perdita della funzione del cervello memorie come simbolo di salute di alzheimer di neurologia e mentale.

RFE60KTF–Ritratto di un medico specialista puntando verso la zona dove la malattia di Alzheimer è situato su un virtuale immagine 3D del cervello

RMDAERKG–Miami Beach Florida, Mount Sinai Medical Center, ospedale, Alzheimer's Disease Research, FL130518004

RFF3H83C–Scansione TC 84 enne maschio con la malattia di Alzheimer. CT mostra atrofia cerebrale con gyri piccoli e grandi sulci

RMBD59K1–Un anziano 73 anno vecchio prendersi cura del suo 71 anni moglie che ha il morbo di Alzheimer, Wales UK

RFRFDXY6–Scienziato detiene il campione di sangue da analizzare Porre rimedio contro il morbo di Alzheimer, immagine concettuale

RFR5CMF1–La proteina tau nella malattia di Alzheimer, illustrazione. Fosforilazione patologica (giallo) di proteine Tau (arancione) mediante chinasi (blu-viola) influenzare le cellule nervose in quello che è chiamato un grovigli neurofibrillari. Questa illustrazione mostra il trasporto di vescicole sinaptiche (rosso-blu sfere) essendo interrotto. Le proteine tau interessano anche microtubles (arancione cilindri). Un grovigli neurofibrillari consiste di anormali aggregati e le fibre insolubili della proteina tau. La proteina tau è un abbondante proteina neurale, le aggregazioni dei quali sono pensati per giocare un ruolo nella malattia di Alzheimer e altri disturbi neurali.

RF2D3AJN4–Placche amiloidi che si formano tra neuroni. Proteina beta-amiloide che disturba la funzione delle cellule nervose in un cervello con malattia di Alzheimer
RFM1C62D–Il morbo di Alzheimer la perdita di memoria a causa di demenza e malattia del cervello con la astratta icona mediche di una testa umana e la ricerca di neurologia come 3D illustrazione

RFE60KW2–Ritratto di un medico specialista puntando verso la zona dove la malattia di Alzheimer è situato su un virtuale immagine 3D del cervello

RFF3H82D–Beta amiloide (Abeta). È come una componente delle placche amiloidi presenti nella malattia di Alzheimer

RMD1X3TW–La malattia di Alzheimer demenza trattamento - Donepezil compresse, il farmaco più comuni utilizzati nel Regno Unito

RFH7Y1WG–La malattia di Alzheimer malattia di Alzheimer il morbo di Alzheimer malattia malato sano medico sanitario con segno

RFTAD78P–La ricerca farmaceutica in patologie cerebrali tra cui la demenza e la malattia di Alzheimer, un tubo eppendorf

RFHYPRDF–Cervello malattie degenerative, morbo di Parkinson, Sinapsi, neuroni, il morbo di Alzheimer, rendering 3D

RFRFDY0R–Il campione di sangue da analizzare Porre rimedio contro il morbo di Alzheimer, immagine concettuale

RFF5PKGD–Il morbo di Alzheimer. Computer illustrazione delle placche amiloidi tra neuroni. Placche amiloidi sono caratteristiche di

RF2FM2W1T–Malattia di Alzheimer. Demenza. Vettore sfondo con neuroni e placche amiloidi (proteina tau che porta alla disintegrazione di microtubuli cerebrali
RFPFF342–Concetto di demenza e la perdita di memoria o di invecchiamento del cervello a causa di malattia di Alzheimer come una icona di medici con foglie di ginkgo biloba è conformato come una testa umana.

RFE60KX5–Ritratto di un medico specialista puntando verso la zona dove la malattia di Alzheimer è situato su un virtuale immagine 3D del cervello

RFF3H83A–Scansione TC 84 enne maschio con la malattia di Alzheimer. CT mostra atrofia cerebrale con gyri piccoli e grandi sulci

RMD1X3TG–La malattia di Alzheimer demenza trattamento - Donepezil compresse, il farmaco più comuni utilizzati nel Regno Unito

RFFCPJAA–La malattia di Alzheimer malattia di Alzheimer il morbo di Alzheimer malattia malato sano medico sanitario con segno

RFHYPRDG–Cervello malattie degenerative, morbo di Parkinson, Sinapsi, neuroni, il morbo di Alzheimer, rendering 3D

RFRFMJB1–Il campione di sangue da analizzare Porre rimedio contro il morbo di Alzheimer, immagine concettuale

RFT0RHRT–Il morbo di Alzheimer prevenzione passi una infografica, uno stile di vita sano e il concetto di benessere

RFF5PKGB–Il morbo di Alzheimer. Computer illustrazione di un neurone sano (sinistra), un neurone con placche amiloidi (giallo, centro), e un

RF2JW33MB–Malattia di Alzheimer. Malattia associata con placche amiloidi, grovigli neurofibrillari, e perdita di connessioni neuronali nel cervello. Cervello umano

RF2A0KBRY–Concetto di perdita della memoria e demenza la malattia e la perdita di funzione cerebrale ricordi come un morbo di Alzheimer salute simbolo di neurologia e problemi mentali.

RFF3H83B–Scansione TC 84 enne maschio con la malattia di Alzheimer. CT mostra atrofia cerebrale con gyri piccoli e grandi sulci

RMD1X3T4–Donepezil compresse, il tablet pc più comuni farmaci per il trattamento di morbo di Alzheimer demenza NEL REGNO UNITO

RFHGE131–La malattia di Alzheimer malattia di Alzheimer il morbo di Alzheimer mal malattia salute sano giovane medico con segno

RFRF4P6X–Scienziato detiene il campione di sangue da analizzare Porre rimedio contro il morbo di Alzheimer, immagine concettuale
RFEKJRX2–Il morbo di Alzheimer, il morbo di Alzheimer'ss malattia, malattia di Alzheimer, atrofia, cervello, la demenza, malattia, disturbo, sanitario, medico, la medicina, la demenza senile, ricerca, petri, pipetta, la ricerca farmaceutica, laboratorio
















































